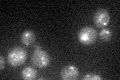
YPL100W
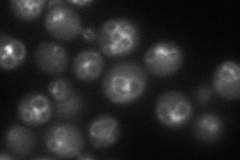
YPL100W
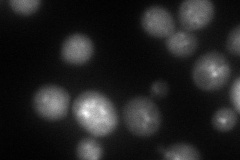
YPL100W
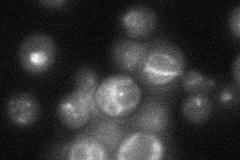
YPL100W
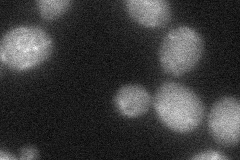
YPL100W
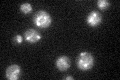
YPL100W

View description
Phosphoinositide binding protein required for vesicle formation in the cytoplasm-to-vacuole targeting (Cvt) pathway; binds both phosphatidylinositol (3,5)-bisphosphate and phosphatidylinositol 3-phosphate; WD-40 repeat protein
Localization:
Intensity:
Fold change:
Significance:
-
C’ GFP library in SD
punctate26.03 -
N' NOP1pr-GFP in SD
punctate,vacuole membrane103.912 -
N' TEF2pr-mCherry in SD
punctate,vacuole membrane74.7975 -
N' NATIVEpr-GFP in SD
vacuole membrane36.0617 -
N' TEF2pr-VC and Cyto-VN in SD
below threshold33.0096 -
C’ GFP library in SD+DTT

punctate32.381.24No -
C’ GFP library in SD+H2O2

punctate26.181No -
C’ GFP library in Starvation Media
punctate35.381.35Yes -
C’ GFP library on the background of Pup2-DaMP

punctate -
C’ GFP library on the background of CCT mutant

punctate26.44121.01532No
